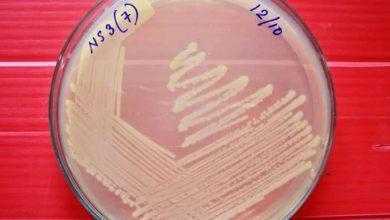
دراسة: بكتيريا مفترسة قد تصبح مضادا حيويا

زيادة الوزن فى أى مرحلة عمرية بعد البلوغ تزيد من خطر الوفاة المبكرة
حذرت دراسة جديدة كبيرة أجراها باحثون بمدرسة هارفارد للصحة العامة وجامعة بوسطن من أن زيادة الوزن فى أى مرحلة من حياة الإنسان ما بعد البلوغ تزيد من مخاطر الوفاة المبكرة.
ووجد الخبراء أن مخاطر الوفاة بأمراض القلب أو السرطان أو المشكلات الصحية الأخرى تتواجد لدى هؤلاء الذين يعانون من زيادة الوزن أو البدانة – حتى ولو بشكل مؤقت – فى أى مرحلة من حياتهم.
وذكرت صحيفة ديلى ميل البريطانية أن علماء قاموا باختبار بيانات من 225 ألف شخص تتراوح أعمارهم بين 25 و91 عاما، لتحليل تاريخ أوزانهم على مدار فترة زمنية بدلا من رصدها فى مرحلة عمرية معينة.
وقال الباحثون إن ذلك كشف أن زيادة الوزن فى أى مرحلة يمكن أن يكون له تأثير ضار على الصحة لاحقا.. وخلص الباحثون إلى أنه كلما ازداد وزن الشخص كلما كان أكثر عرضة لخطر الوفاة المبكرة.
وأوضح الباحثون أنه تم “رصد الارتباط الأقوى على الاطلاق بالوفيات بأمراض القلب والأوعية الدموية” “فبين المجموعة المصابة بزيادة الوزن كانت الخطر للإصابة بأمراض القلب أعلى بنسبة 21% فى حين سجل ارتفاعا شديدا لدى البدناء بشدة ليصل هذا الخطر لنسبة 174%”.
المصدر: اليوم السابع – Annals of Internal Medicine